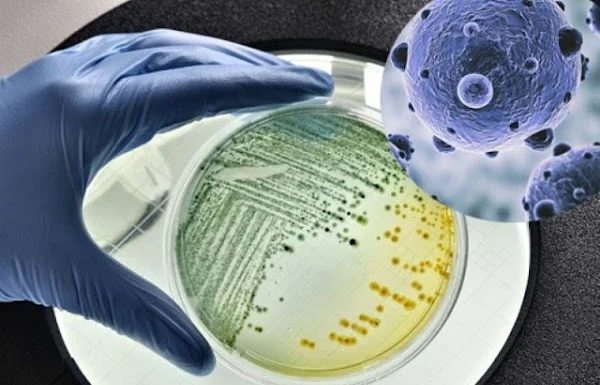
Dirty clogged showerhead breeds diseases, 2 simple ways to clean it sparkling like new

If you're also having this question, don't skip the following article to get the right answer!
Featured
How to store onions, garlic, ginger, and potatoes all year round without sprouting, keeping them fresh and delicious
Administrator - 0
This is how to preserve onions, garlic, and potatoes without mold and sprouting while keeping them fresh throughout the year.
Featured
Don’t waste your money on fresh bamboo shoots if they have this characteristic, bitter and tasteless.
Administrator - 0
Fresh bamboo shoots are a beloved ingredient that can be used to create various delicious dishes. However, not everyone knows how to choose the best quality bamboo shoots.
Featured
Dirty clogged showerhead breeds diseases, 2 simple ways to clean it sparkling like new
Administrator - 0
Many people pay attention to cleaning their homes but often forget about the long-used showerhead that needs regular cleaning and scrubbing.
Featured
Prevent black mold on clothes: Say goodbye to stains and mold with this quick trick!
Administrator - 0
Just with this simple trick, mold and those tiny black spots on your clothes will completely disappear as if brand new.
"A fast-spinning electricity meter is synonymous with high electricity bills. By knowing and applying these 4 tricks to slow down this electricity meter, you can save a significant amount of money on your electricity bills."
Instead of throwing away unfinished beer, why not mix it with toothpaste and use it for these purposes? They will bring unexpected benefits.
Keep your cooking area in the kitchen sparkling clean with the following tile cleaning tips.
Featured
Adding a pinch of salt to your washing machine seems pointless, but in just 5 minutes, you’ll receive unexpected benefits that everyone should know.
Administrator - 0
Add a pinch of salt to your washing machine, and within 5 minutes, you'll experience incredible benefits. Everyone will be eager to learn this amazing trick because every household needs it.
Featured
Extend the lifespan of your vegetables by following this one extra step before storing
Administrator - 0
On many occasions, people tend to buy a large quantity of green onions as they are commonly used in various dishes. To ensure the freshness and prolong the shelf life of green onions, homemakers can follow this simple preservation method.
Most popular
- Advertisement -
Recent posts
Most popular
- Advertisement -
Recent posts
- Advertisement -